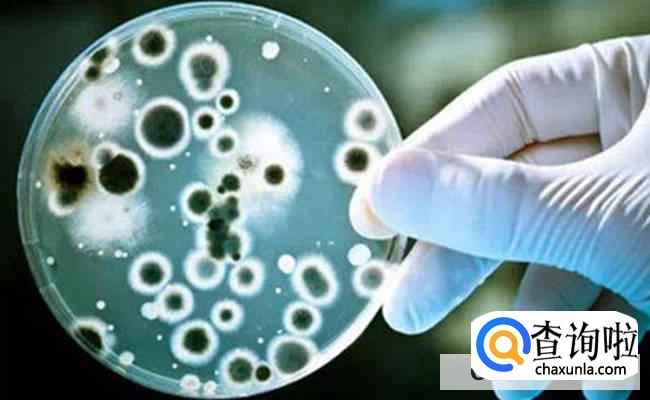
如何减少雾霾对人的危害

如何减少雾霾对人的危害
知识问答小编
0次浏览
2022-10-23 09:34:19
最佳经验
本文由作者推荐
简要回答
简要回答环境污染愈发严重,尤其在寒冷的冬天,供暖地区可能会频频出现雾霾。此时人体吸入雾霾会对呼吸系统肺部造成影响,但有些是因为工作因素不得已接触到雾霾,而我们想要尽可能的降低雾霾对人体的伤害,建议平时少出门。
详细内容
- 01
其中小伙伴要是患有心脑血管类的疾病或者是呼吸系统方面的疾病,在雾霾天气一定要少出门。如果必须出门时戴上口罩,另外开车时不要开窗,要是在家的话,也不要打开门窗。
- 02
平时需要及时补充维生素和微量元素,这样可以尽可能降低雾霾对身体伤害,也能够维护心肺健康,调节自身免疫力。当然也可以适当摄入新鲜的瓜果蔬菜谷类食物。

- 03
平时多喝水,对于雾霾天气有一定缓解作用。毕竟多喝水能够补充液体,增强血液循环。另外提高新陈代谢,还可以降低雾霾对人体皮肤的伤害。

- 04
养成规律的作息习惯,可以有效的提高自身的免疫力。如果碰到雾霾天气,尽量不外出运动,一般在晚上10点之前睡觉,这样可以改善免疫系统。平时在天气晴朗的时候,也可以适当的运动。